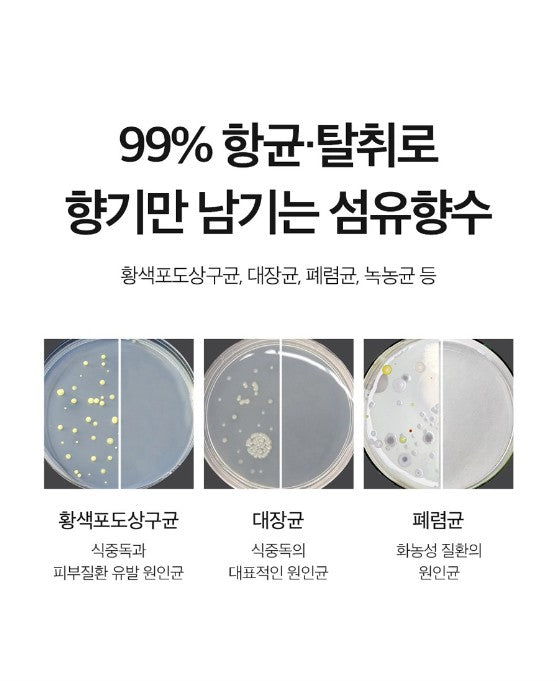

Lovey Dovey
[Lovey Dovey] Fabric Perfume Mist 200ml 9-fragrances deodorization antibacterial Vegan Eco-friendly Green Formula Ecocert EWG Green / from Seoul, Korea
[Lovey Dovey] Fabric Perfume Mist 200ml 9-fragrances deodorization antibacterial Vegan Eco-friendly Green Formula Ecocert EWG Green / from Seoul, Korea
Couldn't load pickup availability
[Main Features]
1. 6 weeks of aging
- You can feel the richness and depth of the fragrance that contains the delicacy of perfumers from England and France through a low-temperature aging process of over 6 weeks.
2. 100% vegan certified
- 100% vegan, eco-friendly recipe that has passed all vegan certification standards, use it with confidence every day
3. Opposition to animal testing
- No animal ingredients, GMO-free
4. Safe use of raw materials
- Aim for green grade considering the environment by containing Ecocert raw materials, and use only raw materials of EWG grades 1 to 3
5. 99% antibacterial and deodorizing
- 99% sterilization of E. coli, pneumococcus, etc.
6. Anti-static and anti-wrinkle all at once
- Improves wrinkles on wrinkled clothes quickly and easily without ironing in busy daily life (there may be differences depending on the fabric)
[Volume]
200ml
[Option]
1. Rosé
- A musk scent of seductiveness and sensuality and a subtle lilac scent that brushes the tip of the nose
2. Pure Clean
- A clean and pleasant warm cotton scent that feels like freshly washed laundry
3. Baby Powder
- Soft and cozy powder scent that feels pure and clean baby's breath
4. Peachsum
- Vibrant, fruity scent with fragrant and sweet peach flesh
5. Eli
- The gentle scent of flowers that you feel in the wind while walking through the flower fields full of jasmine and freesia
6. Chou chou
- When you bite into a ripe peach, the fresh and sweet scent spreads through the air, giving you a fresh and sweet day.
7. Claire
- The cozy and comfortable scent of a duvet filled with cotton wool, and the scent of cotton to decorate the beginning and end of a sweet day
8. Bossolai
- On a sunny day, the fresh scent of soap that is felt from the fresh and clean cotton of Laundry, which is well dried, blends with the citrus scent for a refreshing scent.
9. LeBlanc
- Deep and dark white musk fragrance with delicate floral scents of lily and jasmine and musk
[How to use]
1. After eating, smoking, and exercising, lightly spray 1-2 times on textiles and sports shoes.
2. Lightly spray 1-2 times on bedding, fabric curtains, and fabric sofas that are difficult to wash frequently.
3. After washing, lightly spray 1-2 times when drying the laundry.
* LoveyDovey Brand *
: LoveyDovey wants to apply conscious beauty to fragrance.
Conscious Beauty, which evolved from vegan beauty, focuses on everything that happens on Earth, and extends its reach to the environment.
In order to develop into a conscious beauty brand from a fragrance brand, LoveyDovey practices the followings ;
1. All products vegan certification
2. Continuous win-win CSR project LOVEY BY STEP
3. We care and participate in everything we can do to help the environment, such as switching to packaging that is easier to recycle.
![[Lovey Dovey] Fabric Perfume Mist 200ml 9-fragrances deodorization antibacterial Vegan Eco-friendly Green Formula Ecocert EWG Green / from Seoul, Korea](http://bodasada.myshopify.com/cdn/shop/products/001_fde1434d-b12b-43fc-8e4e-a376cf5ce7b9.jpg?v=1666497960&width=1445)
![[Lovey Dovey] Fabric Perfume Mist 200ml 9-fragrances deodorization antibacterial Vegan Eco-friendly Green Formula Ecocert EWG Green / from Seoul, Korea](http://bodasada.myshopify.com/cdn/shop/products/004_9b3d254f-1530-4c70-bc24-c5891d327efe.jpg?v=1666497959&width=1445)
![[Lovey Dovey] Fabric Perfume Mist 200ml 9-fragrances deodorization antibacterial Vegan Eco-friendly Green Formula Ecocert EWG Green / from Seoul, Korea](http://bodasada.myshopify.com/cdn/shop/products/Screenshot2022-08-10at08.29.32.jpg?v=1666497969&width=1445)
![[Lovey Dovey] Fabric Perfume Mist 200ml 9-fragrances deodorization antibacterial Vegan Eco-friendly Green Formula Ecocert EWG Green / from Seoul, Korea](http://bodasada.myshopify.com/cdn/shop/products/Screenshot2022-08-10at08.31.19.jpg?v=1666497965&width=1445)
![[Lovey Dovey] Fabric Perfume Mist 200ml 9-fragrances deodorization antibacterial Vegan Eco-friendly Green Formula Ecocert EWG Green / from Seoul, Korea](http://bodasada.myshopify.com/cdn/shop/products/Screenshot2022-08-10at08.31.39.jpg?v=1666497971&width=1445)
![[Lovey Dovey] Fabric Perfume Mist 200ml 9-fragrances deodorization antibacterial Vegan Eco-friendly Green Formula Ecocert EWG Green / from Seoul, Korea](http://bodasada.myshopify.com/cdn/shop/products/Screenshot2022-08-10at08.47.04.jpg?v=1666497969&width=1445)
![[Lovey Dovey] Fabric Perfume Mist 200ml 9-fragrances deodorization antibacterial Vegan Eco-friendly Green Formula Ecocert EWG Green / from Seoul, Korea](http://bodasada.myshopify.com/cdn/shop/products/Screenshot2022-08-10at08.47.12.jpg?v=1666497963&width=1445)
![[Lovey Dovey] Fabric Perfume Mist 200ml 9-fragrances deodorization antibacterial Vegan Eco-friendly Green Formula Ecocert EWG Green / from Seoul, Korea](http://bodasada.myshopify.com/cdn/shop/products/Screenshot2022-08-10at08.47.20.jpg?v=1666497966&width=1445)
![[Lovey Dovey] Fabric Perfume Mist 200ml 9-fragrances deodorization antibacterial Vegan Eco-friendly Green Formula Ecocert EWG Green / from Seoul, Korea](http://bodasada.myshopify.com/cdn/shop/products/Screenshot2022-08-10at08.47.32.jpg?v=1666497966&width=1445)
![[Lovey Dovey] Fabric Perfume Mist 200ml 9-fragrances deodorization antibacterial Vegan Eco-friendly Green Formula Ecocert EWG Green / from Seoul, Korea](http://bodasada.myshopify.com/cdn/shop/products/Screenshot2022-08-10at08.47.41.jpg?v=1666497961&width=1445)
![[Lovey Dovey] Fabric Perfume Mist 200ml 9-fragrances deodorization antibacterial Vegan Eco-friendly Green Formula Ecocert EWG Green / from Seoul, Korea](http://bodasada.myshopify.com/cdn/shop/products/Screenshot2022-08-10at08.47.49.jpg?v=1666497958&width=1445)
![[Lovey Dovey] Fabric Perfume Mist 200ml 9-fragrances deodorization antibacterial Vegan Eco-friendly Green Formula Ecocert EWG Green / from Seoul, Korea](http://bodasada.myshopify.com/cdn/shop/products/Screenshot2022-08-10at08.48.02.jpg?v=1666497960&width=1445)
![[Lovey Dovey] Fabric Perfume Mist 200ml 9-fragrances deodorization antibacterial Vegan Eco-friendly Green Formula Ecocert EWG Green / from Seoul, Korea](http://bodasada.myshopify.com/cdn/shop/products/Screenshot2022-08-10at08.29.47.jpg?v=1666497970&width=1445)
![[Lovey Dovey] Fabric Perfume Mist 200ml 9-fragrances deodorization antibacterial Vegan Eco-friendly Green Formula Ecocert EWG Green / from Seoul, Korea](http://bodasada.myshopify.com/cdn/shop/products/Screenshot2022-08-10at08.29.57.jpg?v=1666497968&width=1445)
![[Lovey Dovey] Fabric Perfume Mist 200ml 9-fragrances deodorization antibacterial Vegan Eco-friendly Green Formula Ecocert EWG Green / from Seoul, Korea](http://bodasada.myshopify.com/cdn/shop/products/Screenshot2022-08-10at08.30.07.jpg?v=1666497964&width=1445)
![[Lovey Dovey] Fabric Perfume Mist 200ml 9-fragrances deodorization antibacterial Vegan Eco-friendly Green Formula Ecocert EWG Green / from Seoul, Korea](http://bodasada.myshopify.com/cdn/shop/products/Screenshot2022-08-10at08.30.21.jpg?v=1666497966&width=1445)
![[Lovey Dovey] Fabric Perfume Mist 200ml 9-fragrances deodorization antibacterial Vegan Eco-friendly Green Formula Ecocert EWG Green / from Seoul, Korea](http://bodasada.myshopify.com/cdn/shop/products/Screenshot2022-08-10at08.30.34.jpg?v=1666497965&width=1445)
![[Lovey Dovey] Fabric Perfume Mist 200ml 9-fragrances deodorization antibacterial Vegan Eco-friendly Green Formula Ecocert EWG Green / from Seoul, Korea](http://bodasada.myshopify.com/cdn/shop/products/Screenshot2022-08-10at08.30.43.jpg?v=1666497967&width=1445)
![[Lovey Dovey] Fabric Perfume Mist 200ml 9-fragrances deodorization antibacterial Vegan Eco-friendly Green Formula Ecocert EWG Green / from Seoul, Korea](http://bodasada.myshopify.com/cdn/shop/products/Screenshot2022-08-10at08.30.51.jpg?v=1666497971&width=1445)
![[Lovey Dovey] Fabric Perfume Mist 200ml 9-fragrances deodorization antibacterial Vegan Eco-friendly Green Formula Ecocert EWG Green / from Seoul, Korea](http://bodasada.myshopify.com/cdn/shop/products/Screenshot2022-08-10at08.31.02.jpg?v=1666497960&width=1445)
![[Lovey Dovey] Fabric Perfume Mist 200ml 9-fragrances deodorization antibacterial Vegan Eco-friendly Green Formula Ecocert EWG Green / from Seoul, Korea](http://bodasada.myshopify.com/cdn/shop/products/Screenshot2022-08-10at08.31.11.jpg?v=1666497959&width=1445)

BODASADA
BODASADA is an online commerce that provides the latest Korean premium products at reasonable prices.
We sell stylish, high-quality, good products in various fields such as fashion, lifestyle, and health, and all products are sent directly from Korea.
All shipping processes are filmed with CCTV in order to send the precious products you ordered quickly, accurately and safely.
BODASADA continues to introduce the latest Korean products, and if there are any Korean products you are looking for, please feel free to contact us.
Thank you